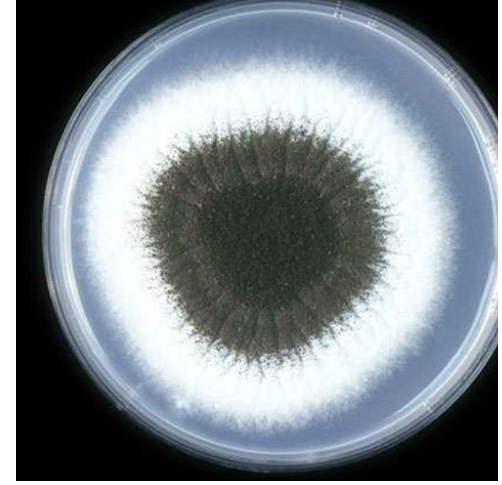
term image
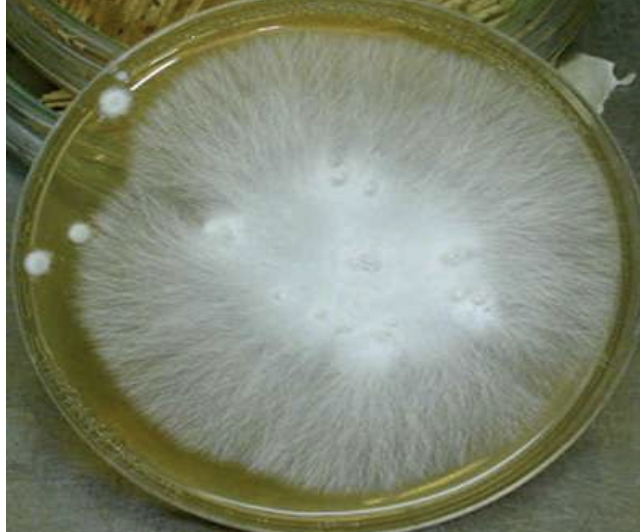
term image
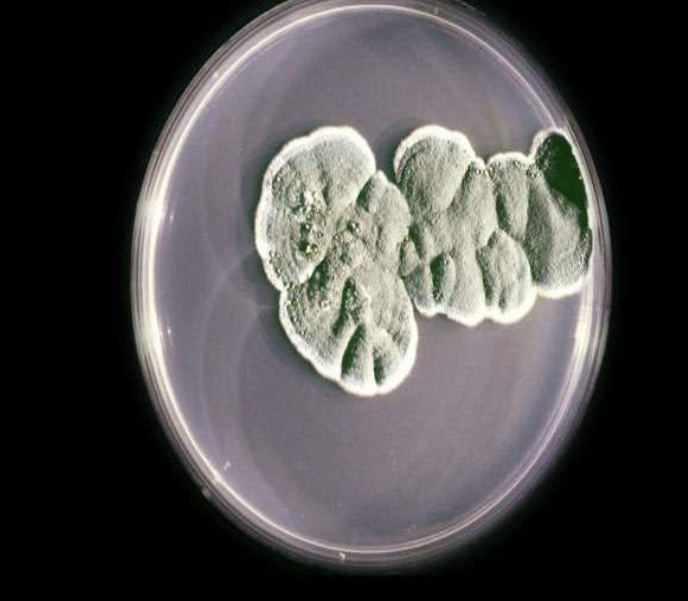
term image
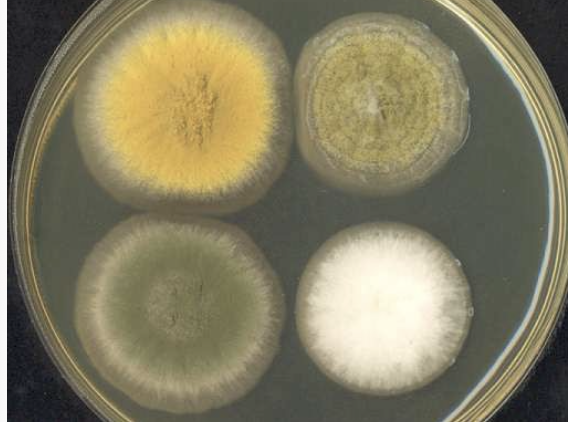
term image
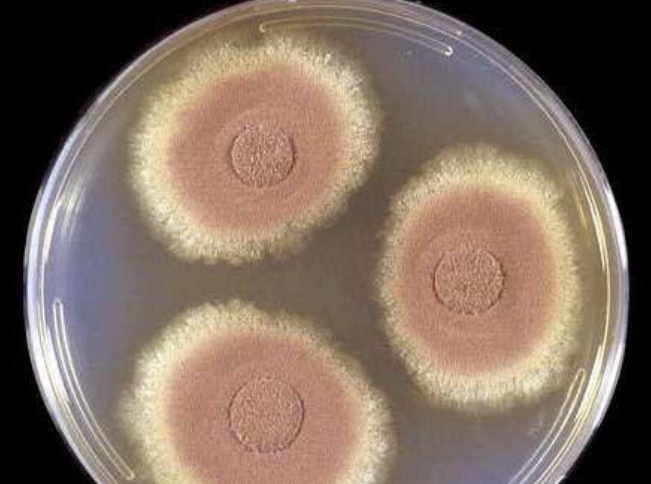
term image
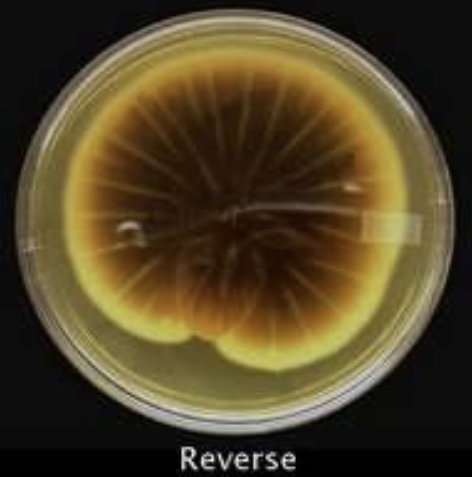
term image

Intro to Mycology
1/24
There's no tags or description
Looks like no tags are added yet.
Name | Mastery | Learn | Test | Matching | Spaced | Call with Kai |
|---|
No analytics yet
Send a link to your students to track their progress
25 Terms
mycology
the study of fungi, their genetic and biochemical properties, their taxonomy, and their use to humans as a source for medicinals and food, as well as their dangers, such as poisoning or infection
teleomorph
aka perfect; sexual form
anamorph
aka imperfect; asexual form; spores are anamorph
thallus

Hypha (pl. hyphae) - Tube-like filament of fungi; grow from elongation at the tips or by branching

hyaline or monilaceous - light-colored/clear
mycelium - masses of hyphae
thallus
thallus - a colony of mold growing on media

Septate hyphae - hyphae that are subdivided into individual cells by transverse walls (septa)
Phaeoid/demataceous - dark color

Vegetative mycelium - grown into or onto agar

Aerial mycelium - extend above agar

spore chain/reproductive mycelium

Aseptate hyphae - hyphae that are not subdivided into individual cells

Macroconidia - Multicelled conidium in which an entire hyphal element converts into a macroconidium. May be thick- or thin-walled; smooth or rough; club-shaped, spindle-shaped, or oval; and alone or in clusters
Conidia = spores (which are anamorph)

Spindle-shaped macroconidia

Microconidia - Single-celled (or rarely two-celled) conidium in which an entire hyphal element converts into the microconidium

macroconidium

microconidium

Chlamydoconidia - Thick-walled hyphal survival conidium formed during poor
environmental conditions, which will germinate and produce conidia when a
better climate occurs
folded
grainy
demataceous

Blastoconidia - May elongate forming hyphae or pseudohyphae

Pseudohyphae - elongated buds that fail to separate and connect with a “link of
sausage” appearance

True “hyphae” - contains no constrictions
or Germ tube - a tubular outpouching without constriction at its base; this is
the initial stage of true hyphae formation